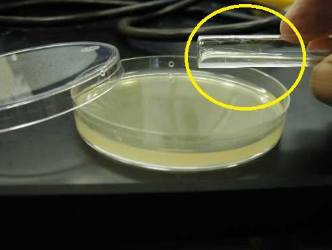
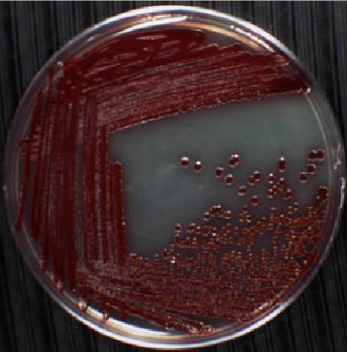
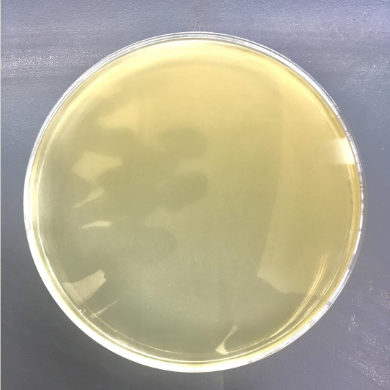
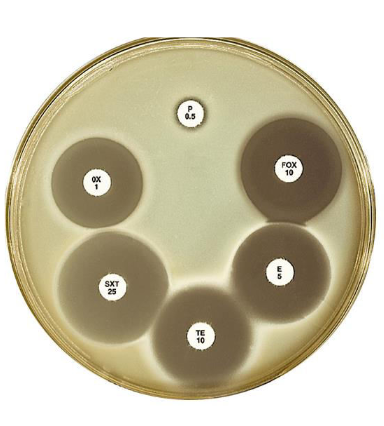
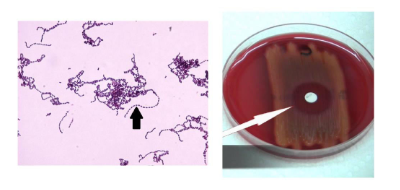
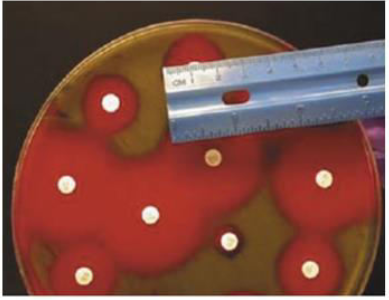
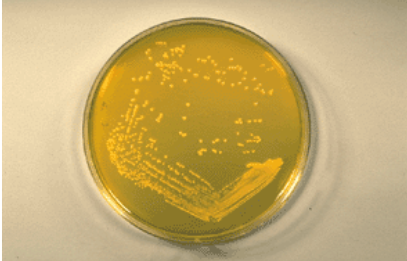
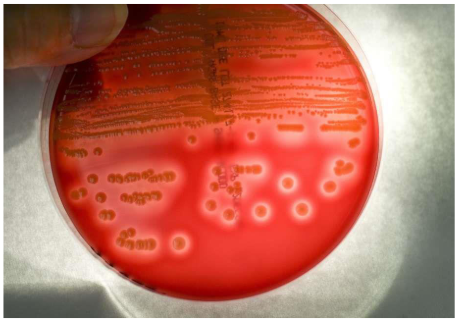
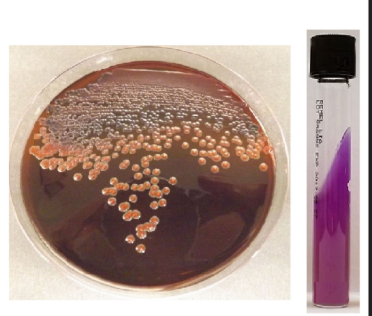
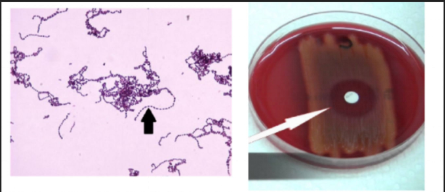

1/126
Looks like no tags are added yet.
Name | Mastery | Learn | Test | Matching | Spaced | Call with Kai |
|---|
No study sessions yet.

Identify the test (Indicate the specific method of the test)
Ziehl-Neelsen method

What is the principle of this test?
Lipid barrier principle

What is the composition of the special structure pointed at?
Polysaccharide

Identify the morphology of the organism pointed at.
Diplococcus

Identify the possible organism giving the characteristic result in the set-up shown.
Escherichia coli

What is/are the physical agent/s of sterilization in this setup? (If there is more than 1 answer, indicate your answers in this format: Arrange answers in alphabetical order following the first letter of the answer. Separate answers with a comma after the first answer then a space before the second answer. EXAMPLE: Physical agent A, Physical agent B)
Autoclave, Hot air
Identify the culture medium (encircled) used in one of the methods in isolating pure culture of microorganisms.
Melted nutrient agar

What is this method of isolating pure culture making use of this culture medium?
Serial dilution pour plate method
Identify method of isolating pure culture of microorganisms.
Four Quadrant Streak Plate method

At which area of the streaking are pure cultures obtained?
Fourth quadrant

Identify the test.
Gram staining

What is the name of the step labeled "D" in this test?
Counterstaining or Secondary staining

: Identify the special structure pointed at. (Answer the specific name of the structure demonstrated by this organism)
Babes-Ernst granules or Volutin granules of BabesErnst

What is the virulence mechanism of this special structure?
Energy reserve

Identify the gram staining reaction and morphology of the organism pointed at.
Gram-negative extracellular diplococci

Identify the representative organism.
Neisseria gonorrheae

Identify the morphology pointed at.
Non-sporing slipping diplobacilli

What is the specific name of the special structure demonstrated by this organism?
Much granules

Interpret the test result. (Do NOT include any punctuation marks in the answer)
Bacteria were killed by iodine in 10 minutes

What is the culture medium used in this test?
Lactose broth with Durham’s fermentation tube

Identify method of isolating pure culture.
Serial Dilution Pour Plate method

In this method, what is the numerical value to use in the computation which represents the diameter of the petri dish used?
62.5S

Identify culture medium.
Nutrient broth

What is the evidence of bacterial growth that can be seen in this culture medium?
Turbidity

Identify the gram staining reaction and morphology of the organism pointed at.
Gram-positive Streptococci

The primary content in the cell wall of this organism is composed of what two (2) substances responsible for its appearance using gram staining test? (Indicate answers in alphabetical order using the first letter of the answer. Separate answers with a comma then a space. EXAMPLE: Answer A, Answer B
Amino acids, disaccharides

Identify the special structure pointed at.
Flagellum

What is the primary virulence mechanism of this special structure?
Motility

What are the compositions of reagent labaled A in this test? (Indicate answers in alphabetical order using the first letter of the answer. Separate answers with a comma then a space. EXAMPLE: Answer A, Answer B)
Concentrated hydrochloric acid, 95% ethanol

What is the name of the reagent labeled B in this test?
Loeffler’s Alkaline Methylene Blue

Identify the physical agent/s that destroyed the microorganism in this test result. (If there is more than 1 answer, arrange answers in alphabetical order using the first letter of the answer. Separate answers with a comma then a space. EXAMPLE: Answer A, Answer B, Answer C)
Autoclave, Hot air

What is responsible for the characteristic result seen in the set-up of the probable organism giving this test result?
Endospores

Identify the specific special structure pointed at.
Endospore

What is the composition of this special structure?
Calcium dipicholinate

Arrange the steps involved in this test in chronological order using the labeled reagents in the set-up. Answer in letters only. (Separate letters with a comma then a space. EXAMPLE: A, B, C, D)
B, C, A, D

What is the primary content in the cell wall of the organisms taking up stain labeled D responsible for its color appearance under this staining test? (Indicate the primary substance only)
Lipopolysaccharides

: Identify culture medium used in the qualitative method for isolating pure culture.
Nutrient agar
: Name the qualitative method for the isolation of pure culture of microorganisms.
Four Quadrant Streak Plate method

What is the description of the morphology pointed at?
In clusters

Identify the representative organism.
Staphylococcus aureus

Identify the organism
Neisseria meningitidis

What is the specimen used in the diagnosis of this organism
Cerebrospinal fluid

Identify the organism
Streptococcus pneumoniae

What enzyme produced by this organism is responsible for the result of the test show in the setup?
Amidase

: In this method of isolating pure culture, identify the area of streaking labeled B.
Second quadrant

Which of the labeled areas of streaking is pure culture obtained? (Answer in letter)
D

Identify the method used in this test.
Kirby-Bauer disk diffusion susceptibility test

What is the streaking used in this test?
Overlapping streak plate method

What is measured to interpret the result of this test?
Zone of inhibition
Interpret the result of penicillin (P) on this test.
Resistant

Name the specific reagent necessary in the staining and demonstration of the structure pointed at.
Tannic acid

What is the composition of the structure pointed at?
Flagellin

What substance is responsible for the characteristic result of the test shown?
Calcium dipicolinate or dipicholinic acid

Interpret the result. (Use standard way of interpretation as transcribed in the live discussion)
Bacteria were killed by autoclave, hot air
Identify the organism. (Indicate the correct way of identifying it)
Group A beta-hemolytic streptococci Streptococcus pyogenes

What is/are responsible for the beta-hemolysis produced by this organism? (If there is more than 1 answer, separate answers with a comma then a space. EXAMPLE: Answer 1, Answer 2)
Streptolysin O, StreptolysinS

Identify the organism.
Staphylococcus epidermidis

What hemolytic pattern in blood agar medium do this organism produce?
Gamma-hemolysis
What is used to standardized the approximate number of bacteria in this test?
0.5 McFarland standard or 0.5 McFarland turbidity standard

What is the culture medium of choice in this test?
Mueller Hinton agar

Which of the labeled reagents in this test intensifies the color of the primary stain to the cell wall of the organism? (Answer in letter)
B

What is the name of reagent "C" employed in this test?
Acetone alcohol

Identify the method in this staining test.
Ziehl-Neelsen method

What group of organisms will reveal staining reaction labeled X?
Non-acid-fast organisms or non acid-fast organisms

Identify the morphology pointed at.
Vibrio

The representative organism with this morphology produces what infection?
Cholera

Identify the organism.
Staphylococcus aureus

What is the name of the pigment produced by this organism?
Lipochrome

What specific component of the culture medium used in this test is responsible for the color appearance of tubes labeled "control" and "5 minutes"?
Andrade’s indicator

: Interpret the result. (Follow the standard interpretation based on what was transcribed in the live discussion)
Iodine killed the bacteria in ten minutes
Identify the culture medium.
Mannitol salt agar

What is/are the characteristic/s of this culture medium? (If there is more than 1 answer, arrange the answers in alphabetical order following the 1st letter. Also, separate the answers with a comma and then a space. EXAMPLE: Answer 1, Answer 2)
Differential, Selective
What is the hemolytic pattern seen in this culture medium?
Beta-hemolysis

The discoloration revealed in this culture medium is what caused by the exposure of what component of this medium?
Trypticase soy agar

Identify the organism.
Neisseria gonorrheae

What is the infection caused by this organism to newborns delivered from an infected birth canal?
Ophthalmia neonatorum

Identify culture medium.
Nutrient broth

What is the characteristic of this culture medium?
Enhancement or enrichment medium

what is the gram staining reaction of this organism?
Gram-positive

The substance in the cell wall of these group of organisms (based on gram staining reaction) responsible for their color appearance is composed of what substance/s? (If there is more than 1 answer, arrange answers in alphabetical order following the 1st letter. Also, separate answers with a comma then a space. EXAMPLE: Substance A, Substance B)
Amino acids, disaccharides

What is the test used to determine the invasiveness of a certain serotype of this organism?
Sereny test

Identify the organism
Escherichia coli

Identify the organism.
Citrobacter freundii

What is responsible for the characteristic butt reaction in the TSI result of this organism?
Cysteinase

Identify the organism.
Mycobacterium tuberculosis

What makes the culture medium in the set up selective to this organism?
Malachite green

Identify the specific special structure pointed at.
Central spore/endospore

What is the virulence mechanism of this special structure?
Resists disinfection

What is/are the reaction/s seen in the culture medium labeled "B"? (If there is more than 1 answer, arrange the answers in alphabetical order following the 1st letter. Also, separate the answers with a comma followed by a space. EXAMPLE: Reaction A, Reaction B)
Hydrogen sulfide production, motility

Which of the labeled culture media shows the complete reaction that can be detected in this medium? (Answer in letter only)
A
Identify the most likely organism.
Enterobacter aerogenes

How are the colonies of this organism typically described? (Answer the description only. Do not include the word "colonies" or "colony")
Fish-eye colonies

Identify the organism
Group A beta-hemolytic Streptococci Streptococcus pyogenes
What is the primary clinical significance associated with this organism?
Strep throat

Identify the organism
Streptococcus pneumoniae

What is the composition of the special structure that is demonstrated by this organism?
Polysaccharide

What is the principle of this test?
Lipid-barrier principle

What is the specimen used in this test?
Sputum

What is the dimension of the smear used in this test in terms of centimeters? (Indicate the number and the word "by" to separate the width and length measurement)
2 centimeters by 3 centimeters

What method is used in this test?
Hucker’s method